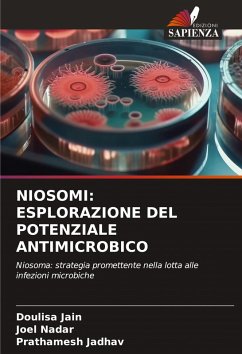

Chimica e potenziale antimicrobico dei tienopirimidinoni
Farmacologia dei nuovi derivati del tienopirimidinone
Versandkostenfrei!
Versandfertig in 6-10 Tagen
35,99 €
inkl. MwSt.

PAYBACK Punkte
18 °P sammeln!
I tienopirimidinoni sono il bioisoster degli eterociclici della chinazolina e, a differenza della chinazolina, esistono tre possibili annulazioni del tiofene all'anello pirimidinico: tieno[2,3-d] pirimidina, tieno[3,2-d] pirimidina e tieno[3,4-d] pirimidina. La moiety dei tienopirimidinoni presenta varie attività come analgesico, antipertensivo, inibitori dell'aggregazione piastrinica, antiprotozoario, broncodilatatore, inibitore della fosfodiesterasi e attività antistaminiche. L'attività antimicrobica di alcuni nuovi derivati di tienopirimidinoni è stata valutata secondo il protocollo sta...
I tienopirimidinoni sono il bioisoster degli eterociclici della chinazolina e, a differenza della chinazolina, esistono tre possibili annulazioni del tiofene all'anello pirimidinico: tieno[2,3-d] pirimidina, tieno[3,2-d] pirimidina e tieno[3,4-d] pirimidina. La moiety dei tienopirimidinoni presenta varie attività come analgesico, antipertensivo, inibitori dell'aggregazione piastrinica, antiprotozoario, broncodilatatore, inibitore della fosfodiesterasi e attività antistaminiche. L'attività antimicrobica di alcuni nuovi derivati di tienopirimidinoni è stata valutata secondo il protocollo standard e tutti i derivati sono risultati ugualmente potenti come un farmaco standard.